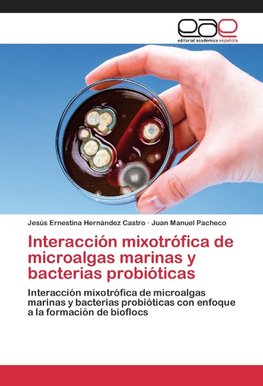
Interacción mixotrófica de microalgas marinas y bacterias probióticas

-
 Španielsky jazyk
Španielsky jazyk
Interacción mixotrófica de microalgas marinas y bacterias probióticas
Autor: Jesús Ernestina Hernández Castro
En este trabajo se evaluó la utilización de cultivos mixotróficos de diferentes especies de microalgas: Grammatophora sp., Schizochytrium sp., Chaetoceros muelleri y una cepa de bacterias ácido lácticas (aislada de tracto digestivo de camarón) en la formación... Viac o knihe
Na objednávku, dodanie 2-4 týždne
48.74 €
bežná cena: 51.30 €
O knihe
En este trabajo se evaluó la utilización de cultivos mixotróficos de diferentes especies de microalgas: Grammatophora sp., Schizochytrium sp., Chaetoceros muelleri y una cepa de bacterias ácido lácticas (aislada de tracto digestivo de camarón) en la formación de bioflocs. Para determinar el efecto de la interacción microalga-probiótico en el crecimiento del cultivo, fueron sembradas las microalgas y probiótico. En ésta etapa se evaluaron los cultivos mediante la adición de una fuente de carbono (melaza) a una concentración de 2 g/m3 de agua cada 4 días, se evaluó el crecimiento de cultivos, la concentración de oxígeno disuelto, formación de bioflocs volumen ocupado por biofloc en 200 mL de cultivo (V:V) y presencia de Vibrio spp. En este trabajo se obtuvo que bajo estas condiciones, a partir del día cuatro de cultivo se presentó la formación de biofloc, generándose la mayor cantidad en el tratamiento a base de Schizochytrium sp. + Probiótico + melaza, con 1.25mL bioflocs/200 mL cultivo. Con estos resultados se propone un sistema biofloc a base de Schizochytrium sp. + Probiótico + Melaza, que puede ser evaluado para el cultivo de especies marinas.
- Vydavateľstvo: Editorial Académica Española
- Rok vydania: 2015
- Formát: Paperback
- Rozmer: 220 x 150 mm
- Jazyk: Španielsky jazyk
- ISBN: 9783847357827

 Anglický jazyk
Anglický jazyk 










